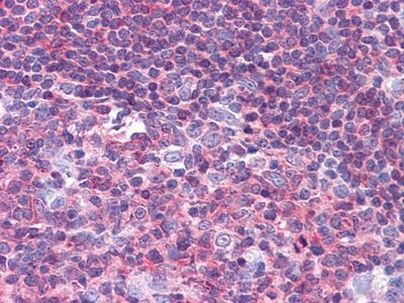
PYK2 Antibody in Immunohistochemistry (Paraffin) (IHC (P))

Search
Invitrogen
PYK2 Monoclonal Antibody (5E2D5)
{{$productOrderCtrl.translations['antibody.pdp.commerceCard.promotion.promotions']}}
{{$productOrderCtrl.translations['antibody.pdp.commerceCard.promotion.viewpromo']}}
{{$productOrderCtrl.translations['antibody.pdp.commerceCard.promotion.promocode']}}: {{promo.promoCode}} {{promo.promoTitle}} {{promo.promoDescription}}. {{$productOrderCtrl.translations['antibody.pdp.commerceCard.promotion.learnmore']}}


Please note: We are reviewing Western blot images included in the antibody testing data in our catalog, including those provided by third parties. Unless expressly labeled or annotated as “raw-unedited”, Western blot images included in the antibody testing data in our catalog may have been edited, optimized or otherwise adjusted for presentation.
产品信息
MA5-15407
种属反应
已发表种属
宿主/亚型
分类
类型
克隆号
抗原
偶联物
形式
浓度
保存液
内含物
保存条件
运输条件
RRID
产品详细信息
MA5-15407 targets PYK2 in indirect ELISA, IHC and WB applications and shows reactivity with Human samples.
The MA5-15407 immunogen is purified recombinant fragment of PYK2 (aa815-997) expressed in E. Coli.
.
MA5-15407 detects PYK2 which has a predicted molecular weight of approximately 115.8kDa.
靶标信息
PTK2B (FAK2) is a cytoplasmic tyrosine kinase involved in calcium-induced regulation of ion channels and activation of the map kinase signaling pathway. PTK2B regulates reorganization of the actin cytoskeleton, cell polarization, cell migration, adhesion, spreading, and bone remodeling. FAK2 plays a role in the regulation of the humoral immune response and is required for normal levels of marginal B-cells in the spleen and normal migration of splenic B-cells. It functions in signaling downstream of integrin and collagen receptors, immune receptors, G-protein coupled receptors, cytokine, chemokine, and growth factor receptors, and mediates responses to cellular stress. Aberrant FAK2 expression may play a role in cancer cell proliferation, migration, and invasion in tumor formation and metastasis. Elevated expression has been seen in gliomas, hepatocellular carcinoma, lung cancer, and breast cancer.
仅用于科研。不用于诊断过程。未经明确授权不得转售。
生物信息学
蛋白别名: FADK; FAK; FAK1; FRNK; pp125FAK